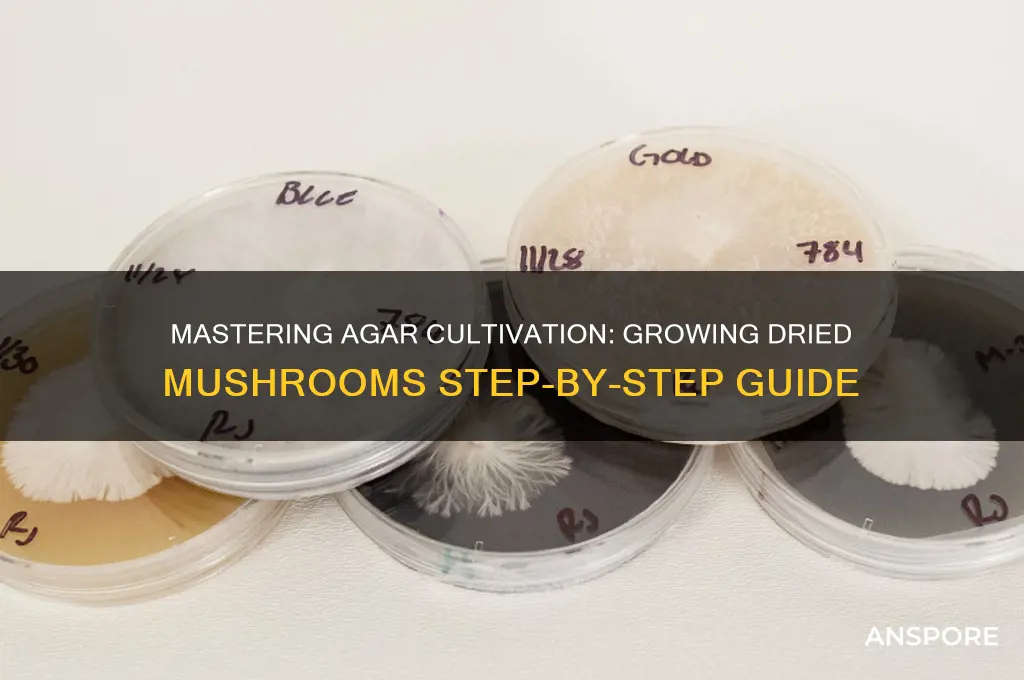
how to grow dried mushrooms in agar

Growing dried mushrooms in agar is a fascinating and precise process that allows cultivators to isolate and propagate specific mushroom strains in a sterile environment. Agar, a gelatinous substance derived from seaweed, serves as a nutrient-rich medium that supports mycelial growth, the vegetative part of the fungus. To begin, dried mushroom tissue or spores are rehydrated and transferred to an agar plate, where they can grow undisturbed. This method is particularly useful for cloning desired mushroom varieties, preserving genetic purity, and studying fungal biology. Success hinges on maintaining strict sterility to prevent contamination, making it essential to work in a clean environment and use sterilized tools. With patience and attention to detail, agar cultivation offers a reliable way to nurture mushrooms from their earliest stages.
| Characteristics | Values |
|---|---|
| Substrate | Agar (typically potato dextrose agar or malt extract agar) |
| Mushroom Type | Dried mushroom species suitable for agar cultivation (e.g., Psilocybe, Oyster, Lion's Mane) |
| Sterilization | Autoclave agar at 121°C (250°F) for 15-30 minutes to sterilize |
| Inoculation | Use sterile technique to transfer mycelium or spore solution to agar plate |
| Incubation | Incubate at 22-28°C (72-82°F) in darkness for 7-14 days |
| Contamination Prevention | Work in a sterile environment (e.g., still air box or laminar flow hood) |
| Transfer to Bulk Substrate | Once colonized, transfer mycelium to a bulk substrate (e.g., grain, straw) for fruiting |
| Fruiting Conditions | Maintain high humidity (85-95%), indirect light, and temperatures between 18-24°C (64-75°F) |
| Harvesting | Harvest mushrooms when veils break or caps start to flatten |
| Storage of Dried Mushrooms | Store dried mushrooms in airtight containers in a cool, dark place |
| Rehydration | Rehydrate dried mushrooms in warm water for 15-20 minutes before use |
| Success Rate | Varies by species and technique; generally 60-90% success with proper sterilization |
| Equipment Needed | Sterile agar plates, pressure cooker/autoclave, inoculation tools, incubation chamber |
| Time Frame | 4-8 weeks from inoculation to harvest, depending on species and conditions |
Explore related products
What You'll Learn
- Sterilizing Equipment: Autoclave tools, ensure cleanliness to prevent contamination during the mushroom cultivation process
- Preparing Agar Plates: Mix agar, nutrients, and water, pour into plates, sterilize for a solid medium
- Inoculating Agar: Transfer mushroom mycelium to agar plates using sterile techniques to start growth
- Incubating Plates: Maintain optimal temperature and humidity for mycelium colonization, typically 22-26°C
- Transferring Mycelium: Once colonized, move mycelium to bulk substrate for fruiting body development

Sterilizing Equipment: Autoclave tools, ensure cleanliness to prevent contamination during the mushroom cultivation process
Sterilizing your equipment is a critical step in growing mushrooms from dried cultures on agar. Contamination from bacteria, mold, or other microorganisms can quickly ruin your entire project. The autoclave is the gold standard for sterilization in mushroom cultivation, as it uses high-pressure steam to kill all living organisms, including spores. Before beginning, ensure your autoclave is functioning properly and that you understand its operation. Gather all the tools you’ll need, such as Petri dishes, scalpel blades, inoculation loops, and agar media containers. Clean these items thoroughly with soap and water to remove any visible debris, then rinse them with distilled water to avoid mineral residue. This initial cleaning step is essential, as the autoclave sterilizes but does not clean.
Once your equipment is cleaned, prepare it for autoclaving. Wrap metal tools like scalpels and inoculation loops in aluminum foil or place them in a metal tray to prevent them from becoming projectiles under pressure. Glassware, such as Petri dishes and media bottles, should have their lids loosely fitted to allow steam penetration while preventing breakage. Label all containers with their contents and the date of sterilization. Arrange the items inside the autoclave chamber, ensuring there is enough space for steam to circulate freely. Overcrowding can lead to inadequate sterilization. Follow the manufacturer’s instructions for your autoclave, typically running a cycle at 121°C (250°F) for 15-30 minutes, depending on the load size.
After the autoclave cycle is complete, allow the chamber to depressurize naturally. Do not force open the autoclave, as this can be dangerous and may contaminate your sterilized equipment. Once the pressure gauge reads zero, carefully remove the items and let them cool in a clean, sterile environment. Avoid placing them on unsterilized surfaces or in areas prone to airborne contaminants. If you’re working in a home setup, a still-air box or laminar flow hood can provide a sterile workspace for handling sterilized equipment. Store sterilized items in sealed containers or plastic bags until you’re ready to use them.
Maintaining cleanliness throughout the sterilization process is paramount. Work in a clean area, wear sterile gloves, and use a lab coat or apron to minimize the introduction of contaminants. If you don’t have access to an autoclave, pressure cooking can be a makeshift alternative, though it may not achieve the same level of sterilization. However, for reliable and consistent results, investing in or accessing an autoclave is highly recommended. Proper sterilization ensures that your agar media and tools remain free from competing organisms, giving your mushroom mycelium the best chance to grow without interference.
Finally, always double-check your sterilization procedures before proceeding with inoculation. Even a small oversight can lead to contamination, wasting time, resources, and effort. Keep a log of your sterilization cycles, including dates and contents, to maintain consistency and track any issues. By prioritizing cleanliness and using an autoclave effectively, you’ll create a solid foundation for successful mushroom cultivation on agar. Remember, sterilization is not just a step—it’s a mindset that ensures the integrity of your entire cultivation process.
Mushrooms in Tree Trunks: Unveiling the Hidden Forest Fungi
You may want to see also

Preparing Agar Plates: Mix agar, nutrients, and water, pour into plates, sterilize for a solid medium
To begin preparing agar plates for growing dried mushrooms, you'll need to gather the necessary materials: agar powder, a nutrient source (such as potato dextrose or malt extract), distilled water, and petri dishes or other suitable containers. The agar will serve as the solidifying agent, while the nutrients will provide the essential elements for fungal growth. Start by measuring the required amount of agar powder, typically around 15-20 grams per liter of water, and combine it with the nutrient source according to the manufacturer's instructions or a trusted recipe. This mixture will form the basis of your agar plates.
Next, add the distilled water to the agar and nutrient mixture, stirring thoroughly to ensure complete dissolution. Heat the solution gently, either on a stovetop or in a microwave, until it reaches a rolling boil. This step is crucial for sterilizing the mixture and ensuring that any contaminants are eliminated. Maintain the boil for a few minutes, then remove the solution from the heat source and let it cool slightly. The goal is to achieve a temperature that allows you to handle the liquid without risking burns, yet remains hot enough to pour smoothly.
Once the agar solution is ready, carefully pour it into the petri dishes or containers. Work in a clean, sterile environment to minimize the risk of contamination. Fill each plate to about one-third to one-half full, leaving enough space for the agar to solidify without spilling over. Ensure that the plates are placed on a level surface to allow for even distribution of the agar. If you're using multiple plates, pour the solution into each one swiftly to maintain the agar's temperature and prevent premature solidification.
After pouring, allow the agar plates to cool and solidify at room temperature. This process typically takes around 30-60 minutes, depending on the volume and ambient conditions. Avoid disturbing the plates during this time to prevent introducing contaminants or creating imperfections in the agar surface. Once solidified, the agar should appear clear and firm, providing a stable medium for mushroom mycelium to grow.
Finally, sterilize the agar plates to ensure they are free from any remaining contaminants. This can be achieved by autoclaving, a process that uses high-pressure steam to kill microorganisms. If an autoclave is not available, pressure cooking or other sterilization methods may be used, but autoclaving is the most reliable technique. After sterilization, allow the plates to cool before storing them in a clean, sealed container or using them immediately for inoculation with dried mushroom spores or tissue. Properly prepared and sterilized agar plates are essential for successful mushroom cultivation, providing a controlled environment for mycelial growth.
Exploring Utah's Wilderness: Do Psychedelic Mushrooms Thrive Here?
You may want to see also

Inoculating Agar: Transfer mushroom mycelium to agar plates using sterile techniques to start growth
Inoculating agar plates with mushroom mycelium is a critical step in cultivating mushrooms from dried cultures, requiring precision and sterile techniques to prevent contamination. Begin by preparing your workspace, ensuring it is clean and free from drafts. Sterilize all equipment, including your hands, with 70% isopropyl alcohol. Assemble your materials: sterile agar plates, a scalpel or inoculation loop, a flame source (such as a Bunsen burner or alcohol lamp), and your dried mushroom culture or spore syringe. The goal is to transfer a small piece of mycelium or a few spores onto the agar surface without introducing contaminants.
Next, flame-sterilize your inoculation tool by passing it through the flame until it glows red, allowing it to cool slightly before use. If using a dried mushroom culture, rehydrate a small piece in sterile water for a few minutes to revive the mycelium. For spore syringes, shake the syringe gently to suspend the spores evenly. Remove the lid of the agar plate briefly, ensuring it remains in the sterile workspace, and flame the lip of the plate to kill any surface contaminants. Quickly transfer the lid to one hand while holding the plate in the other, minimizing exposure to the environment.
With your sterilized tool, carefully collect a small piece of rehydrated mycelium or a drop of spore solution. Lift the lid slightly, and inoculate the agar by gently placing the mycelium or spores onto the surface. Avoid touching the agar or the plate’s inner walls. Replace the lid immediately and secure it with sterile tape if necessary. Label the plate with the date and type of mushroom culture for future reference. Proper inoculation ensures the mycelium has a clean medium to colonize, setting the foundation for successful growth.
Maintaining sterility throughout the process is paramount. Work quickly but deliberately, and always flame your tools and the plate’s lip before and after inoculation. If using a glove box or still air box, ensure it is properly set up to provide a sterile environment. After inoculation, incubate the agar plates in a dark, warm area (around 22-26°C) for 7-14 days, depending on the mushroom species. Monitor the plates for signs of contamination, such as unusual colors or odors, and discard any compromised plates immediately.
Finally, once the mycelium has fully colonized the agar plate, it can be used to expand the culture or transfer to grain spawn for further growth. This step is essential for reviving dried mushroom cultures and establishing a healthy mycelium network. By following these sterile techniques and paying close attention to detail, you can successfully inoculate agar plates and take the first step in growing mushrooms from dried cultures.
Can Brown Mushrooms Thrive on Soul Sand? Exploring Minecraft's Unique Biomes
You may want to see also
Explore related products

Incubating Plates: Maintain optimal temperature and humidity for mycelium colonization, typically 22-26°C
Incubating agar plates is a critical step in growing dried mushrooms, as it provides the ideal environment for mycelium colonization. To ensure successful growth, maintaining the correct temperature range of 22-26°C (72-79°F) is essential. This temperature range mimics the natural conditions that mushrooms thrive in, promoting healthy and vigorous mycelium development. A consistent temperature within this range prevents the mycelium from growing too slowly or becoming stressed, which can lead to contamination or poor colonization.
To achieve and maintain the optimal temperature, consider using an incubation chamber, such as a still air incubator or a DIY setup with a heating pad and thermostat. Place the agar plates inside the chamber, ensuring proper air circulation to prevent hotspots or cold spots. Monitor the temperature regularly using a reliable thermometer or temperature controller to make adjustments as needed. Avoid placing the incubator in direct sunlight or near drafts, as these can cause fluctuations in temperature and humidity.
Humidity control is equally important during incubation, as it helps prevent the agar from drying out and supports mycelium growth. Aim for a relative humidity level of around 60-70% within the incubation chamber. This can be achieved by placing a tray of water or a humidifier inside the chamber to add moisture to the air. Alternatively, use a humidity-controlled incubator or a plastic container with a lid to create a humid environment. Regularly check the humidity levels using a hygrometer and adjust as necessary to maintain the desired range.
When incubating agar plates, it's crucial to minimize disturbances to the mycelium. Avoid opening the incubation chamber unnecessarily, as this can introduce contaminants and cause temperature and humidity fluctuations. If you need to inspect the plates, do so quickly and with clean hands or gloves to reduce the risk of contamination. Keep the incubation area clean and sanitized, and ensure that all equipment and tools used in the process are properly sterilized to maintain a sterile environment.
The duration of incubation can vary depending on the mushroom species and the specific conditions, but generally, it takes 7-14 days for the mycelium to fully colonize the agar plate. During this time, monitor the plates regularly for signs of contamination or abnormal growth. If contamination occurs, remove the affected plate immediately to prevent it from spreading to other plates. With proper temperature and humidity control, and a clean, sterile environment, you can expect healthy mycelium colonization and successful mushroom growth. Remember to be patient and allow the mycelium sufficient time to grow, as rushing the process can compromise the final results.
Lion's Mane Mushroom Growth Speed: Unveiling the Fascinating Timeline
You may want to see also

Transferring Mycelium: Once colonized, move mycelium to bulk substrate for fruiting body development
Once your mycelium has fully colonized the agar, it’s time to transfer it to a bulk substrate to initiate fruiting body development. This step is crucial for transitioning from the sterile, nutrient-rich agar environment to a more natural growing medium where mushrooms can form. Begin by preparing your bulk substrate, which typically consists of a mixture of materials like straw, wood chips, or compost, sterilized to eliminate contaminants. Ensure the substrate is cooled to room temperature before use to avoid damaging the mycelium. Sterilization can be done using a pressure cooker or autoclave, depending on the volume of substrate. Proper sterilization is essential, as any competing organisms can hinder mycelium growth and fruiting.
Next, create a sterile environment for the transfer process. Work in a still air box or a clean, draft-free area to minimize the risk of contamination. Using a sterile tool, such as a scalpel or inoculation loop, carefully cut a small piece of colonized agar containing healthy mycelium. Alternatively, if you’ve expanded the mycelium to grain spawn, use a sterile spoon or scoop to transfer a portion of the colonized grain. Introduce the mycelium or grain spawn into the bulk substrate, ensuring even distribution throughout the material. Mix gently but thoroughly to allow the mycelium to come into contact with as much substrate as possible, promoting rapid colonization.
After transferring the mycelium, place the bulk substrate in a container with small holes for ventilation, such as a plastic tub or grow bag. Maintain a warm, humid environment, typically around 70-75°F (21-24°C), to encourage mycelium growth. Keep the substrate moist but not waterlogged, as excess moisture can lead to mold or bacterial growth. Mist the substrate lightly with water if it begins to dry out, and ensure proper airflow to prevent stagnation. Over the next few weeks, the mycelium will colonize the bulk substrate, breaking down the material and preparing for fruiting.
Once the substrate is fully colonized, it’s time to induce fruiting conditions. This involves exposing the mycelium to cooler temperatures, higher humidity, and indirect light. Transfer the colonized substrate to a fruiting chamber, such as a humid tent or greenhouse, and maintain temperatures between 60-70°F (15-21°C). Increase humidity to around 90-95% by misting the walls of the chamber or using a humidifier. Introduce fresh air periodically to provide the carbon dioxide needed for mushroom development. Within a week or two, small pins (the beginnings of mushrooms) should start to form, eventually growing into mature fruiting bodies ready for harvest.
Throughout the fruiting process, monitor the environment closely to ensure optimal conditions. Adjust humidity and ventilation as needed, and protect the growing mushrooms from pests like fungus gnats. Harvest the mushrooms when the caps are fully open but before the spores drop, as this ensures the best flavor and texture. After harvesting, the substrate may still have enough mycelium to produce a second or third flush, so maintain fruiting conditions and monitor for additional growth. Properly managed, this transfer and fruiting process allows you to cultivate a bountiful harvest of mushrooms from your initial agar culture.
Rapid Oyster Mushroom Growth: Secrets to Speedy Harvesting
You may want to see also
Frequently asked questions
Agar is used as a solidifying agent in mushroom cultivation to create a sterile, nutrient-rich medium where mushroom mycelium can grow. It provides a stable surface for mycelium to colonize and prevents contamination, making it ideal for isolating and expanding mushroom cultures from dried mushroom tissue.
To prepare agar, mix a nutrient-rich recipe (e.g., potato dextrose agar or malt extract agar) with water, heat it to dissolve the agar, and sterilize it using an autoclave or pressure cooker. Once cooled, pour the agar into sterile Petri dishes or containers, allow it to solidify, and then inoculate it with dried mushroom tissue or spores in a sterile environment.
Sterility is crucial to prevent contamination. Work in a clean, sterile environment like a still air box or laminar flow hood. Sterilize all tools (e.g., scalpels, tweezers) with alcohol or flame, and ensure your hands are clean. Use sterile techniques when transferring mushroom tissue to the agar, and seal the containers properly to avoid exposure to airborne contaminants.











































